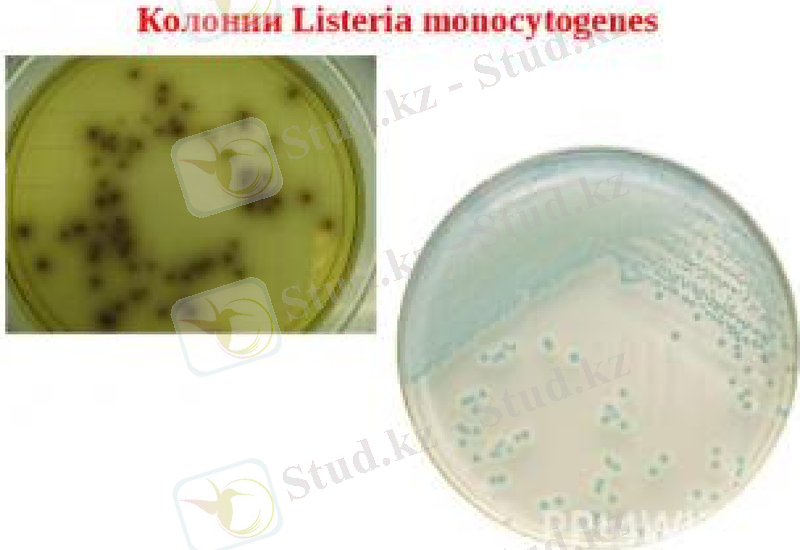
Slide 10

Листериялар: морфологиясы, физиологиясы, антигендері, лабораториялық диагностикасы, алдын алу және емі



Тақырыбы: Листериялар. Листериялардың морфологиясы, физиологиясы, антигендері. Лабораториялық диагностика. Алдын алу және емдеу

Жоспар
Листериозға сипаттама
Таксономиясы, морфологиясы, дақылдандыруы
Ферменттік белсенділігі, антигендік қасиеті, патогенділік факторлары
Эпидемиологиясы, патогенезі
Емдеуі және профилактикасы
Пайдаланылған әдебиеттер тізімі



Листериоз -Listeria monocytogenes қоздыратын, фекальды-оральды жолмен берілетін, клиникалық көрінісі полиморфизммен ерекшеленетін жұқпалы ауру, оның ішінде менингиттік, сепсистік және жүктілерде ұрықты зақымдайтын түрлері жиі кездеседі. Листериоз қоздырғышын М. Хапфес 1911 жылы ашқан.

Таксономиясы
Тұқымдастығы: Lactobacillaceae
Туыстастығы: Listeria
Түрлері : L. innocua, L. monocytogenes, L. welshimeri, L. iwanovii, L. rayi, L. murrayi.
Listeria туыстастығына бактерияның 6 түрі кіреді.
Адамдар мен жануарларға тек қана L. monocytogenes(16 серовары бар) патогенді, ал L. iwanovii жануарларға патогенді.

Морфологиясы
L. Monocytogenes -қысқа, аздап иілген, грам оң, полиморфты, қозғалмалы таяқша. Жағындыда бір-біріне қатарласып немесе бұрыш құрып жиі орналасады. Талшықтары және капсуласы бар, спора түзбейді.


Дақылдандыру
Листериоз қоздырғышы -факультативті анаэроб, кеңінен қолданатын қоректік орталарда сілтілі жағдайда және 37С температурада өседі (бірақ нашар өседі) . Қан қосылған қоректік ортада жақсы өседі -ұсақ, жартылай мөлдір, нәзік гемолиз аймағы бар колониялар түзеді. Кейбір штамдары сары немесе қызыл пигмент түзеді. Микроаэрофильдер болғандықтан 5-10% CO2 бар атмосферада жақсы дамиды.

Ферменттік белсенділігі
Биохимиялық белсенділігі төмен
-Глюкозаны қышқылға дейін ыдыратуы мүмкін;
-Индол, күкіртті сутек бөлмейді;
-желатинді ыдыратпайды;
-каталаза түзеді.

Антигендік қасиеті
Листериялар 16 серологиялық варианттардан тұрады, оның ішінде 15 соматикалық О антигенге және 5 флагеллярлық Н антигенге ие.

Патогенділік факторлары
Эндотоксин түзеді. Эндотоксиннің гемолитикалық және лецитовителлазалық белсенділігі бар, моноциттерді ынталандырушы қасиетке ие. Патогенді листерияларда биологиялық белсенді молекулалар мен ақуыздар жиынтығы кездеседі(листериолизин О, фосфолипаза С, лецитиназа, интерналин, ActA және PrfA ақуыздары) .

Эпидемиологиясы
Листериоз сапронозды инфекцияларға жатады, сыртқы қоршаған орта негізгі тіршілік ететін орны. Листериялар сүр шөпте және басқа малазықтық өсімдіктерде анықталған.

Таралу жолдары
Алиментарлы
Ет, сүт, сыр, көкөністі қолданғанда. Сонымен қатар, су, қарым-қатынас (ауру жануарды күткенде жұқтырады) арқылы таралуы мүмкін. Ауа-шаң арқылы жұғуы -жануарлардың жүнін, терісін өңдеген кезде болады.

Инфекция көзі

Көп жағдайда инфекция бірен-саран кездесіп отырады. Листериоз жүкті әйелдерге өте қауіпті, себебі, олардың иммундық статусы төмен
20-30
Листериозбен ауыратындар жүкті әйелдер. Инфекция трансплацентарлық жолмен ұрыққа беріледі, соның нәтижесінде мерзімнен бұрын немесе ұрық өлі туады, туған соң ақаулар дамуынан қайтыс болады. Тасымалдаушылық болу мүмкін, ұзақтығы анықталмаған.

Листериоз жүкті әйелдерге өте қауіпті
Егер жүкті әйелдердің анамнезінде келесідей аурулар болатын болса, жедел листериоздың диагностикасына жіберу керек:
Қайталама ангина;
Грипптәрізді аурулар;
Кардиологиялық мәселелер;
Рецидивті конъюнктивит;
Аборт;
листериоз
Кіші жамбас мүшелерінің қабынулық аурулары;
Зәр шығару жолдарының рецидивті аурулары
Өлі туылған ұрық

Клиникасы
Жасырын кезені 3 аптадан - 70 күнге дейін.
ОЖЖ зақымдалуы ( менингиттер, энцефалиттер, мидың абсцессі, психоздар), кей кезде баспа, сепсис, сүзек түрінде өтеді. Ағымы бойынша жедел, жедел асты және созылмалы.

Патогенезі
Листериоз көбінесе әлсіреген иммундық статус негізінде дамиды. Жүктілер ЖИТС-пен ауыратын немесе АИВ-жұқтырылғандар арасында және де басқа да иммундық патологиясы бар науқастарда жиі кездеседі. Эпителиялық және эндотелиялық жасушалардың зақымдануы салдарынан бактериемия, бауыр, көкбауыр, лимфа түйіндерінің, жүйке жүйесінің зақымдалуы байқалады.

Патогенезі
Ішкі ағзаларда зақымдалған жасушаларда түйіншектер -листериомалар түзіліп, келесі кезеңінде листериомалардың некрозы мен ағзалардың дистрофиясы дамиды. Бұл созылмалы түрлердің дамуына әкеледі.

Ену қақпасы
Инфекцияның ену қақпасы -көбінесе ас қорыту, тыныс алу жолдарының шырышты қабығы, жарақаттанған тері болады. Листериялар ыдырағанда ағзада интоксикация туғызатын эндотоксин бөледі. Фагоциттердің зақымдалуы нәтижесінде иммундытапшылық жағдайы асқынады.

Емдеуі
Антибиотиктер тағайындалады. 2-6 апта бойында ампициллин мен гентамицинді клиникалық көріністеріне қарап тағайындайды.

Диагностика
Зерттеу әдістері:
Бактериологиялық
Серологиялық
Аллергиялық
ПТР
Жеделдетілген әдіс
ИФР
Калина модификациясы бойынша грамша бояу

Серологиялық әдістер: КБР, қос сарысумен қойылатын жанама гемагглютинациялық реакция, ИФТ және листериозды диагностикуммен қойылатын АР (динамикалық түрде) жүргізіледі. Молекулалық-генетикалық әдіс: ПТР

Профилактика
Арнайы профилактикасы жоқ. Бейспецификалық сақтандыру жүргізіледі. Инфекция ошағында жануарлардың еті мен сүтін тек жоғарғы температурамен өңдеуден кейін ғана пайдаланады. Жүкті әйелдерде жануарлармен қатынасты болдырмау.

Пайдаланылған әдебиеттер
Медициналық микробиология Б. А. Рамазанова,
https://ru. wikipedia. org/wiki/%D0%9B%D0%B8%D1%81%D1%82%D0%B5%D1%80%D0%B8%D0%B8
- Іс жүргізу
- Автоматтандыру, Техника
- Алғашқы әскери дайындық
- Астрономия
- Ауыл шаруашылығы
- Банк ісі
- Бизнесті бағалау
- Биология
- Бухгалтерлік іс
- Валеология
- Ветеринария
- География
- Геология, Геофизика, Геодезия
- Дін
- Ет, сүт, шарап өнімдері
- Жалпы тарих
- Жер кадастрі, Жылжымайтын мүлік
- Журналистика
- Информатика
- Кеден ісі
- Маркетинг
- Математика, Геометрия
- Медицина
- Мемлекеттік басқару
- Менеджмент
- Мұнай, Газ
- Мұрағат ісі
- Мәдениеттану
- ОБЖ (Основы безопасности жизнедеятельности)
- Педагогика
- Полиграфия
- Психология
- Салық
- Саясаттану
- Сақтандыру
- Сертификаттау, стандарттау
- Социология, Демография
- Спорт
- Статистика
- Тілтану, Филология
- Тарихи тұлғалар
- Тау-кен ісі
- Транспорт
- Туризм
- Физика
- Философия
- Халықаралық қатынастар
- Химия
- Экология, Қоршаған ортаны қорғау
- Экономика
- Экономикалық география
- Электротехника
- Қазақстан тарихы
- Қаржы
- Құрылыс
- Құқық, Криминалистика
- Әдебиет
- Өнер, музыка
- Өнеркәсіп, Өндіріс
Қазақ тілінде жазылған рефераттар, курстық жұмыстар, дипломдық жұмыстар бойынша біздің қор #1 болып табылады.



Ақпарат
Қосымша
Email: info@stud.kz